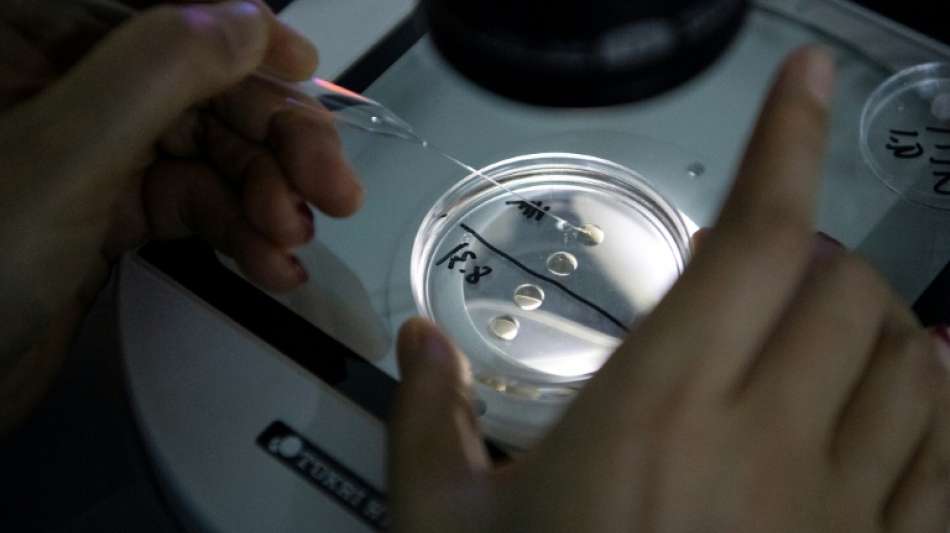

US-Paar verklagt Kinderwunschklinik nach Verwechslung
In Kalifornien hat ein Paar eine Spezialklinik für künstliche Befruchtung verklagt, weil ihr Neugeborenes genetisch das Kind anderer Eltern war. In der am Montag bei Gericht in Los Angeles eingebrachten Klageschrift heißt es, die Embryonen zweier Paare seien in der Klinik "wahrscheinlich aus Nachlässigkeit" vertauscht und jeweils der falschen Frau eingepflanzt worden.
Als Daphna und Alexander Cardinale im September 2019 zum ersten Mal ihr Neugeborenes erblickten, bemerkten sie, dass das kleine Mädchen dunklere Haut und Haare als der Rest der Familie hatte. Die anschließenden Tests hätten ergeben, dass das Baby von Alexander und Daphna "keinerlei genetische Verbindung" zu ihnen hatte, hieß es in der Erklärung der Anwaltskanzlei Peiffer Wolf. "Ihr Baby war das biologische Kind von absolut Fremden."
Die beiden betroffenen Paare nahmen Kontakt zueinander auf und kamen überein, sich jeweils ihre biologischen Kinder zu übergeben. Der Tausch wurde inzwischen gerichtlich besiegelt.
Die Cardinales verlangen aber von der Klinik Schadenersatz für durch die Verwechslung erlittenes Leid. "Die Geburt unserer Tochter sollte einer der schönsten Momente meines Lebens sein - aber ich war sofort erschüttert und verwirrt durch die Tatsache, dass ich sie nicht erkannte", sagte Alexander Cardinale.
Die Kinder schließlich auszutauschen sei einmal mehr erschütternd gewesen. "Das Kind zu verlieren, das man kennt, für das genetische Kind, das man noch nicht kennt - das ist wirklich ein Albtraum."
(A. Madsen--BTZ)

 Berlin
Berlin

 München
München
 Hamburg
Hamburg
 Düsseldorf
Düsseldorf
 Frankfurt am Main
Frankfurt am Main
 Potsdam
Potsdam
 Leipzig
Leipzig
 Dortmund
Dortmund
 Hannover
Hannover
 Köln
Köln
 Kiel
Kiel
 Bremen
Bremen
 Flensburg
Flensburg
 Rostock
Rostock



